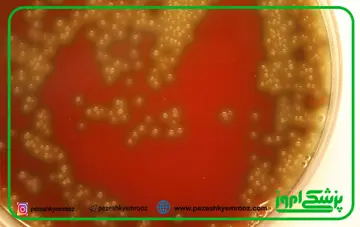

99-225
با توجه به نتایج اولیه در مورد رمدسیویر، سازمان غذا و دارو با صدور مجوز استفاده اضطراری از آن در اول ماه می سال ۲۰۲۰ (اصلاح شده در ۲۸ آگوست سال ۲۰۲۰) را صادر کرد تا از رمدسیویر برای درمان بزرگسالان و کودکان بستری در بیمارستان با ابتلای مشکوک یا تایید آزمایشگاهی کووید -۱۹ استفاده شود. رمدسیویر در همان زمان در چند کشور دیگر نیز تایید کامل یا مشروط را دریافت کرده است.